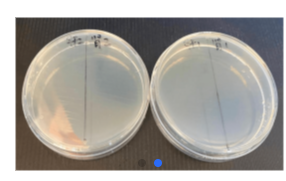

一种厨房器具的盖子其他2026-02-13
一种厨房器具的盖子其他2026-02-13 2-噻唑甲醛-6-吲哚席夫碱的结构、制备和用途其他2026-02-13
2-噻唑甲醛-6-吲哚席夫碱的结构、制备和用途其他2026-02-13 2-噻唑甲醛-4-吡啶席夫碱的结构、制备和用途其他2026-02-13
2-噻唑甲醛-4-吡啶席夫碱的结构、制备和用途其他2026-02-13 2-噻唑甲醛-糠醛席夫碱的结构、制备和用途其他2026-02-13
2-噻唑甲醛-糠醛席夫碱的结构、制备和用途其他2026-02-13 2-噻唑甲醛-2-吡啶席夫碱的结构、制备和用途其他2026-02-13
2-噻唑甲醛-2-吡啶席夫碱的结构、制备和用途其他2026-02-13 2-噻唑甲醛-苯席夫碱的结构、制备和用途其他2026-02-13
2-噻唑甲醛-苯席夫碱的结构、制备和用途其他2026-02-13 一种有机电解质体系锂空气电池直接活化方法其他2026-02-13
一种有机电解质体系锂空气电池直接活化方法其他2026-02-13 一种导电胶体电解质锂空气电池的组装方法化学化工2026-02-13
一种导电胶体电解质锂空气电池的组装方法化学化工2026-02-13 一种具有阳离子传感性能的Zn-MOF材料及制备方法其他2026-02-13
一种具有阳离子传感性能的Zn-MOF材料及制备方法其他2026-02-13 一种钆簇配合物磁制冷材料及合成方法其他2026-02-13
一种钆簇配合物磁制冷材料及合成方法其他2026-02-13







 材料科学领域专家
材料科学领域专家 化学工程领域专家
化学工程领域专家 材料科学领域专家
材料科学领域专家 功能材料领域专家
功能材料领域专家 纺织科学技术领域专家
纺织科学技术领域专家 生物医疗领域专家
生物医疗领域专家 自动化仪表领域专家
自动化仪表领域专家 动力与电气领域专家
动力与电气领域专家
 辽宁省朝阳市光电装备产学研联盟
辽宁省朝阳市光电装备产学研联盟 宏达机械与东北林业大学产学研联盟
宏达机械与东北林业大学产学研联盟 朝阳辽宁极恒甘薯产学研联盟
朝阳辽宁极恒甘薯产学研联盟 辽宁浪马轮胎高性能轮胎产学研联盟
辽宁浪马轮胎高性能轮胎产学研联盟 零冷水燃气热水器用膨胀式阻水罐
零冷水燃气热水器用膨胀式阻水罐 鲫鱼疱疹病毒病复合疫苗制剂及制备方法和应用
鲫鱼疱疹病毒病复合疫苗制剂及制备方法和应用 高光谱数据在碳汇气体监测中的应用
高光谱数据在碳汇气体监测中的应用 虚拟现实场景在现实中的应用
虚拟现实场景在现实中的应用 一种交流调压电路及其控制方法
一种交流调压电路及其控制方法 实时无损定量细胞力学双谐振压电技术
实时无损定量细胞力学双谐振压电技术 一种无触点功率限制器
一种无触点功率限制器 细晶高强钢筋及方钢管在建筑中应用的关键技术
细晶高强钢筋及方钢管在建筑中应用的关键技术 畜禽功能性益生菌产品开发
畜禽功能性益生菌产品开发 柑橘育种技术及新品种成果
柑橘育种技术及新品种成果











